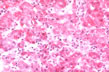

|
Fig 44 - FOCAL NECROSIS: A focal area where a group of hepatocytes are necrotic and the area is infiltrated by inflammatory cells which in this case are mainly lymphocytes. Other times the reaction may be histiocytic as for example in granulomatous lesions. A light lesion.
|
Fig 45 - MULTIFOCAL NECROSIS: PaMultiple focal areas of liver cell damage that can be very serious. In this slide the damaged cells are the light ones which have lost their glycogen content represented by the red granular material that stains red with the PAS reaction.
 |
Fig 46 - CONFLUENT NECROSIS: This necrosis is not spotty but involves masses of cells distributedi a certain region of the lobule and therefore it is:
1-ZONAL when it affects one of the 3 zones of the lobule:
centrolobular, perilobular, midlobular.
2-BRIDGING when it occurs between the portal fields and central veins: porto-portal, porto-central, central-central.